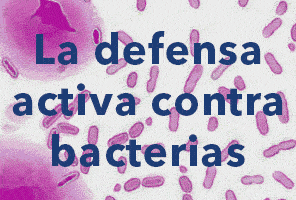
BioMar

COMUNICACIÓN
Madrid, 13/02/2026 | El 94% de los encuestados considera que la acuicultura española está al nivel o por encima de las principales potencias internacionales del sector
ARTÍCULO PATROCINADO
ETIQUETADO ERRÓNEO
ANALISIS
MULTITRÓFICO
REPRODUCCIÓN
A FONDO
MERCADO
PATROCINADO